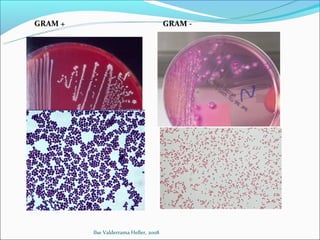
GRAM +                                  GRAM -




         Ilse Valderrama Heller, 2008

Este documento define la microbiología como la ciencia que estudia los seres vivos microscópicos. Explora las ramas de la microbiología como la bacteriología, micología, virología y parasitología. También describe las características y clasificaciones de bacterias, virus, hongos, protozoos y helmintos.